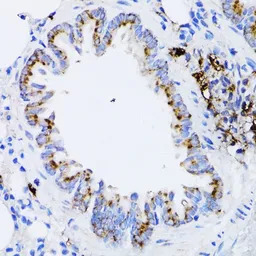
Retinoic Acid Receptor alpha a

相关产品推荐更多 >
万千商家帮你免费找货
0 人在求购买到急需产品
- 详细信息
- 文献和实验
- 技术资料
- 免疫原:
Recombinant fusion protein containing a sequence corresponding to amino acids 1-457 of human RARA (NP_001019980.1).
- 亚型:
IgG
- 形态:
Liquid
- 保存条件:
Store as concentrated solution. Centrifuge briefly prior to opening vial. For short-term storage (1-2 weeks), store at 4ºC. For long-term storage, aliquot and store at -20ºC or below. Avoid multiple freeze-thaw cycles.
- 克隆性:
Polyclonal
- 标记物:
Unconjugated
- 适应物种:
Human, Mouse, Rat
- 保质期:
12 months from the shipping date of the product.
- 抗原来源:
Human
- 目录编号:
GTX54703
- 级别:
Primary Antibodies
- 库存:
Available
- 供应商:
GeneTex
- 宿主:
Rabbit
- 应用范围:
WB, IHC-P
- 浓度:
Batch dependent (Please refer to the vial label for the specific concentration.)
- 靶点:
Retinoic Acid Receptor alpha
- 抗体英文名:
Retinoic Acid Receptor alpha antibody
- 抗体名:
Retinoic Acid Receptor alpha 抗体
- 规格:
100 μl

IHC-P analysis of rat brain tissue using GTX54703 Retinoic Acid Receptor alpha antibody.
Dilution : 1:100

IHC-P analysis of mouse cerebellum tissue using GTX54703 Retinoic Acid Receptor alpha antibody.
Dilution : 1:100

WB analysis of various sample lysates using GTX54703 Retinoic Acid Receptor alpha antibody.
Dilution : 1:1000
Loading : 25μg per lane
IHC-P analysis of rat lung tissue using GTX54703 Retinoic Acid Receptor alpha antibody.
Dilution : 1:100
风险提示:丁香通仅作为第三方平台,为商家信息发布提供平台空间。用户咨询产品时请注意保护个人信息及财产安全,合理判断,谨慎选购商品,商家和用户对交易行为负责。对于医疗器械类产品,请先查证核实企业经营资质和医疗器械产品注册证情况。
 文献和实验
文献和实验Liu H et al., Front Neurosci 2021 (PMID:33994921)
Sonoda H et al., J Cell Biochem 2019 (PMID:31056772)
Fluorescence-Based Technique for Analyzing Retinoic Acid
Retinoic acid (RA) is a potent transcriptional activator whose actions are mediated by members of the nuclear hormone receptor family. In addition to playing key roles in embryonic development and in tissue maintenance
In situ hybridisation to alpha satellite sequences (chromosome specific)
Alpha satellite sequences, whilst highly repetitive, are specific to each individual chromosome. These sequences flank the centromeres and can present a target measured in megabases. In this protocol a biotin or digoxigenin labelled DNA
of pluripotent P19 cells into skeletal muscle lineage by using histone deacetylase inhibitor, valproic acid and the ligand of retinoic acid receptor, all-trans retinoic acid.
 技术资料
技术资料暂无技术资料 索取技术资料





![ICAM2 antibody [mIC2/4 (3C4)] (Low endotoxin, azide free)](https://img1.dxycdn.com/2022/0328/257/8053088236824400453-14.jpg!wh200)
![ALDH7A1 antibody [04]](https://img1.dxycdn.com/2022/0328/987/4118929145438700453-14.png!wh200)




